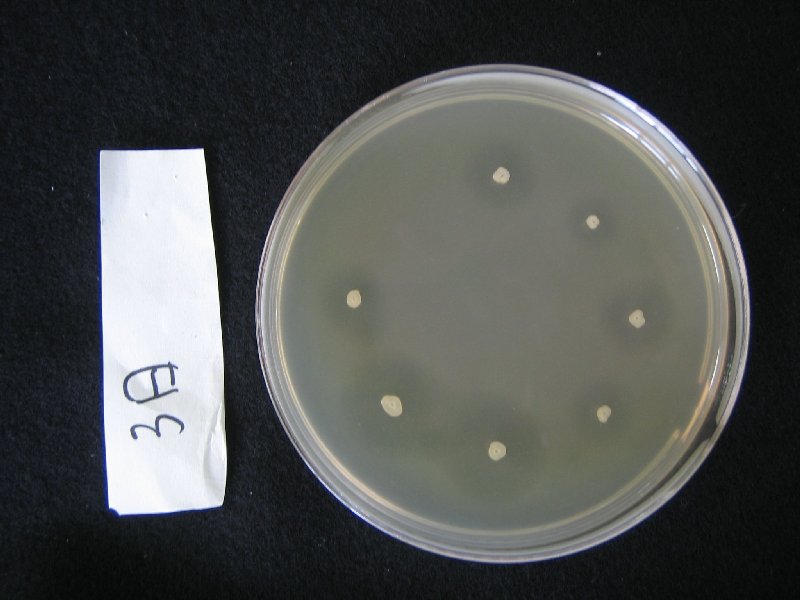

![]() |
海洋バイオマスの利活用を目指した研究
近年,海洋バイオマスの有効利用が注目されています。我々は,多くの産業分野で利用されている海藻多糖類(アルギン酸やフコイダン)に着目し,その分解酵素の探索を行っています。これまでに海藻多糖類資化性菌のスクリーニングを行い,その菌から新規のアルギン酸分解酵素を得ることに成功しています。
|
![]() |
ジオバチラス属好熱菌の高度利用
ジオバチラス属細菌は,地球上に広く分布した中等度好熱菌で,高温(約60℃)で良好に増殖します。好熱菌にも関わらず寒い環境からも頻繁に見出され,単離株の個性も様々です。我々は「ジオバチラス属細菌は優れた環境適応能力をもつ」と見込んでおり,その能力の解析や応用に関する研究を幅広く行っています。マリアナ海溝の深海底泥に由来する株を実験対象としてきましたが,近年では海藻資化性や高形質転換性の株なども対象にしています。
|
![]() |
好熱菌適応進化工学の創生へ
ジオバチラス属細菌を,耐熱化指向性の酵素進化工学に利用する研究をしています。酵素は優れた触媒ですが,その不安定性から実用化が難しいものがあります。このような不安定性は酵素を熱に強くする(耐熱化する)だけで大きく改善されることから,その作業を簡略できれば,酵素の産業利用を促進できるはずです。高変異性好熱菌を利用した酵素進化や,好熱菌を用いて耐熱化酵素をスクリーニングする手法などを集中的に研究しています。
|
![]() |
アミロイド線維の分子機構および特性解析
アルツハイマー病やパーキンソン病,II型糖尿病等はタンパク質の異常凝集が原因の一つとして考えられています。これらは総称してアミロイド病と呼ばれており,タンパク質の異常凝集を抑制することが発症予防につながります。アミロイド病の発症予防に「医食同源」を提案し, 日本に豊富に存在し馴染みのある海藻に着目して, 海藻成分からアミロイド線維形成を阻害する物質の探索とその機能について調べています。
|
![]() |
魚動脈球からエラスチン繊維の精製
資源の再利用は循環型社会における重要な位置付けになっており,魚の廃棄部位である動脈球から医療・美容分野での利用が期待される弾性繊維エラスチンの精製とその特性評価に取り組んでいます。エラスチンの減少は皺や動脈硬化の原因とされています。魚からのエラスチンの精製は,哺乳類よりも安全性が高く,また廃棄部位の利用は健康増進と資源の再利用の両方を満たしていることから, 今後の研究の展開が期待されています。
|